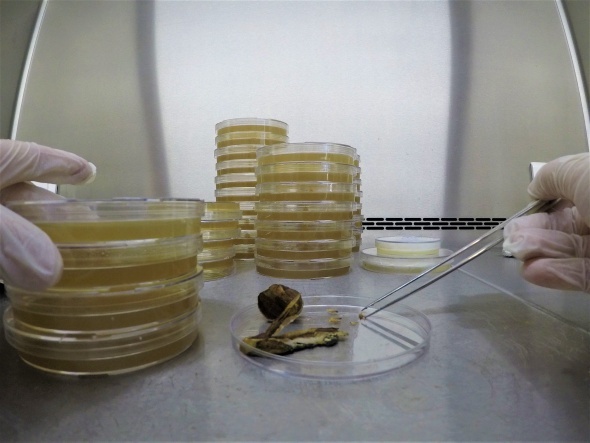
...

Son Dakika
|
ASAYİŞ
Fatih’te bitişik halde bulunan 2 gecekondu çöktü: Yaralılar var!
Katar’da askeri helikopter kazası: 3 Türk personel şehit
Trump, Hürmüz Boğazı’nı açması için İran’a 48 saat süre verdi
Ordu’da kıyıya insansız deniz aracı vurdu
MHP ve DEM Parti bayramlaştı: "Terörsüz Türkiye" süreci öne çıktı
Arakçi: "Hürmüz Boğazı açık, temas halinde güvenli geçiş sağlamaya hazırız"
Bağcılar TEM’de yolcu otobüsü alevlere teslim oldu
ABD, İran petrolünün satışına 30 gün süreyle izin verdi
Bayram günü mahalle savaş alanına döndü: 3 ölü, 22 yaralı
1
Üzerinde özel bir ekibin çalıştığı mantar için tavuk kümesi üretim haneye çevrildi. Hedef ise yurt dışına ihraç etmek.
2
Halk arasında Kırmızı Reishi mantarı olarak bilinen ve uzakdoğuda yaklaşık 2 bin yıldır kullanılan Ganoderma Lucidum, Düzce Üniversitesi Geleneksel ve Tamamlayıcı Tıp Merkezi tarafından oluşturulan özel bir ekip sayesinde üretilmeyi başardı.
3
İlk olarak üniversite içinde bulunan laboratuvarda üzerinde çalışılan Kırmızı Reishi mantarı, çoğaltılarak üretim aşamasına geçildi. Mantar üzerinde çalışan Prof. Dr. Ertuğrul Kaya ve öğretim görevlisi Selime Semra Erol’un üzerinde çalıştığı ve ürettirmeyi başardığı mantarın analizler rakamları ise yurt dışını solladı.
4
Tavuk kümesi Reishi mantarı çiftliği oldu
Geçtiğimiz Mayıs ayında Düzce Üniversitesi merkezi gen bankasına ait Ganoderma Lucidum spawnlarının ilk ekimi gönüllü çiftçi ile beraber gerçekleştirildi. Üretim tamamen organik olarak gerçekleştirilirken, üretim sürecinin hiç bir aşamasında sentetik kimyasal madde kullanılmadı. 2020 Ekim ayında ise ilk hasat yapıldı. Düzce Gölyaka ilçesi Sarıdere Köyü’nde çiftçiye ait atıl durumda bulunan tavuk çiftliği, modern bir mantar üretim tesisi olacak şekilde tasarlandı.
5
Kırmızı Reishi mantarı hakkında bilgi veren , Düzce Üniversitesi Geleneksel ve Tamamlayıcı Tıp Merkezi Müdürü Prof. Dr. Ertuğrul Kaya, “Latince ismi Ganoderma lucidum. Son yıllarda batının ve ülkemizin de tanımış olduğu özellikle geleneksel tıpta tıbbi amaçlar için kullanılan mantar türüdür. Ülkemizde son yıllarda yaygınlaşmaya başladı. Farklı kullanım alanları var. Farklı kullanım şekilleri var.
6
Ülkemizde de doğal olarak yetişen bir mantardır. Aslında fakat çok tanınmıyordu, yemek için uygun bir mantar değil. Odunsu bir yapısı var. Daha çok çay şeklinde demlenerek kullanılan bir mantar türü. Özellikle bağışıklığı güçlendirdiğine dair, bazı kanser tiplerinde etkili olduğuna dair bilimsel çalışmalar yapılmış ve araştırma yayınlanmıştır.
7
Halk arasında rehavet gören tüketilen bir mantardır. Uzak doğuda binlerce yıldır bilinen bir mantardır. Özellikle uzak doğuda bu mantar ölümsüzlük mantarı ismiyle bilinir. İnsanlar ömürleri boyunca bu mantarları belirli miktarlarda, sürekli olarak tüketirler. Bunun tıbbi olarak kendilerine faydalı olduğuna inanırlar.
8
Son yıllarda yapılan bilimsel araştırmalarda bazı konularda bunun faydalı olduğunu çağrıştırmaktadır. Ülkemizde bu ürünün farklı şekillerde satışı var. Özellikle kapsül şeklinde çay, kahve olarak satışı var. Ciddi şekilde tüketimi var. Tıbbi amaçlı olarak ve vatandaşlarımız bundan çok fayda gördüklerini düşünüyorlar, bunu ifade ediyorlar. Ülkemizde bu tüketimi karşılayan bir üretim yok” dedi.
9
“6 ila 8 kat daha güçlü, kilosu 3 bin lira”
Mantarı laboratuvar ortamından çıkartıp pilot uygulamasını yaptıklarını ifade eden Kaya, “Bir çiftçimizle anlaşmalı olarak, kendi küçük ortamında üretimini de gerçekleştirdik. İlk ürünün satışını da gerçekleştirerek amacına ulaştık. Çalışmalarımız devam ediyor. Daha büyük ölçekli üretimlere de devam edeceğiz. Amacımız Türkiye’de tüketilen Ganoderma Lucidum mantarının tamamının Türkiye’de üretilmesi. Süreç içerisinde ihracat kapasitesini sağlanarak, uygun olan yerlere ihracatının yapılması. Yurt dışından şuan ekstraklı olarak alınmaktadır.
10
Kendi ürettiklerimizle yurt dışından gelenlerin içerik analizlerini de yaptık. İçerik analizlerinde ortalama olarak 6 ila 8 kat daha iyi olduğumuzu tespit ettik. Bu çalışmalar kapsamında gerçek anlamda ticaret olarak rekabet edebilir ve üreticisine kazandırabilecek bir ürün. İlk denememiz de başarılı olduk. İlk çiftçimiz satışını yaptı ve parasını da kazandı. Ganoderma lucidum toptan ve parkende olarak farklı fiyatlardan tüketiliyor.
Önerilen Haberler
Öne Çıkan Yerel Haberler
İlişkili Yerel Haberler